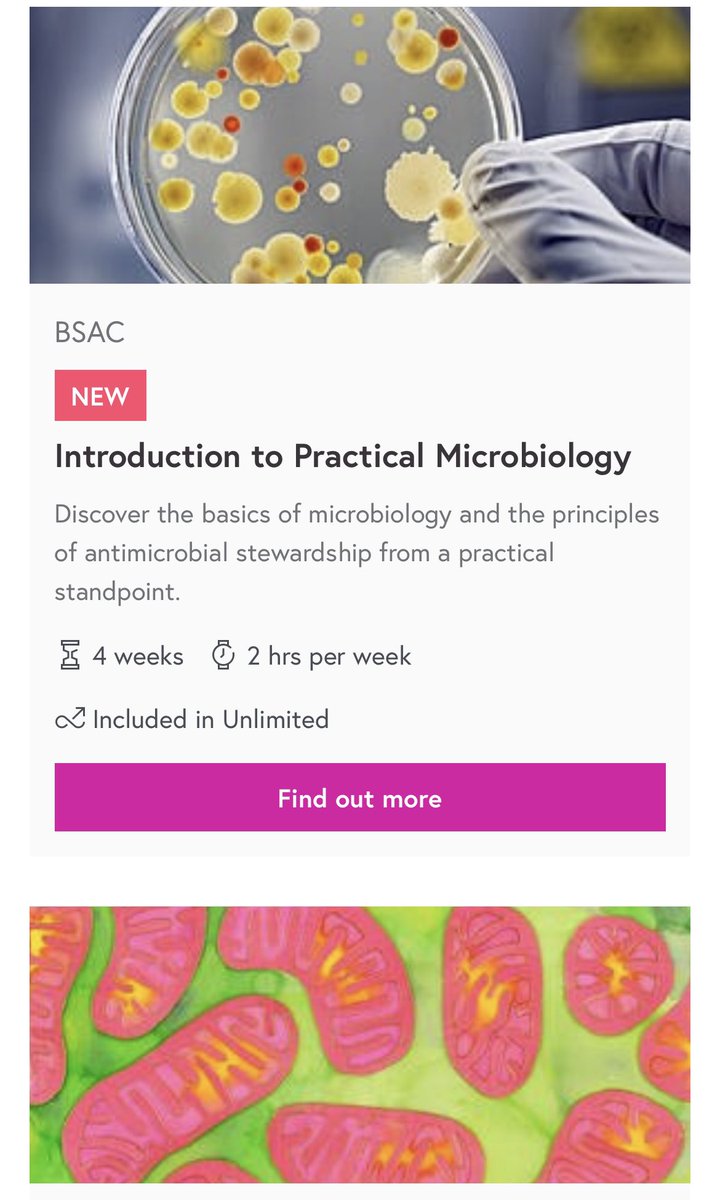

١-هنا عدة كورسات اونلاين و مجانية في تخصصات الاحياء تقدمها جامعة هارفرد الشهيرة
online-learning.harvard.edu
online-learning.harvard.edu
٢- هنا كورسات متنوعة مجانية من عدة جامعات شهيرة علي منصة edx و في تخصصات متعددة منها الأحياء الجزيئية و الاعصاب و التشريح و التغذية و الوراثة و المجاهر و المعلوماتية الوراثية
edx.org
edx.org
٣- هنا أكثر من ٥٣٤ كورس بيولوجي على منصة كلاس سينترل ،،
ملاحظة اختاروا الكورسات المجانية
classcentral.com
ملاحظة اختاروا الكورسات المجانية
classcentral.com
٥- هنا عدد كبير جداً من الكورسات البيولوجيه على منصة courses الشهيرة،
اختار ما يناسبك و ما يفيدك في تخصصك و ابتعد عن التشتت،
coursera.org
اختار ما يناسبك و ما يفيدك في تخصصك و ابتعد عن التشتت،
coursera.org
جاري تحميل الاقتراحات...